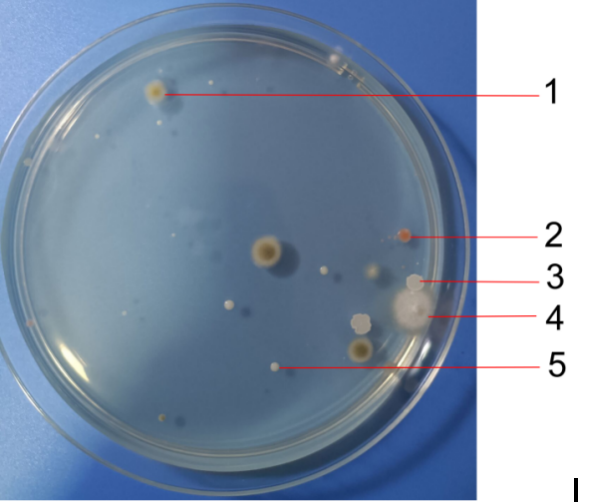
4FACD
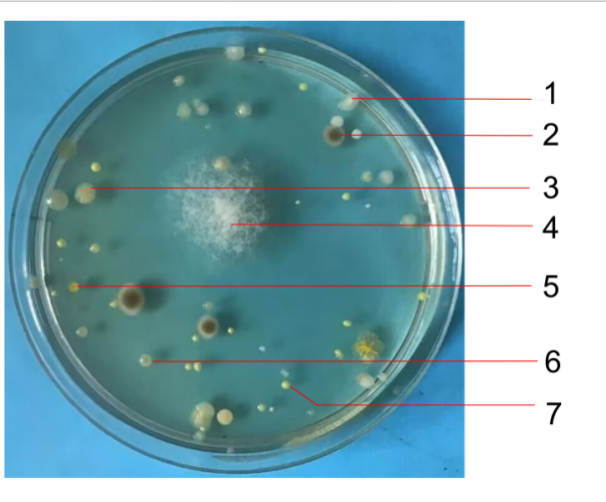
528D5
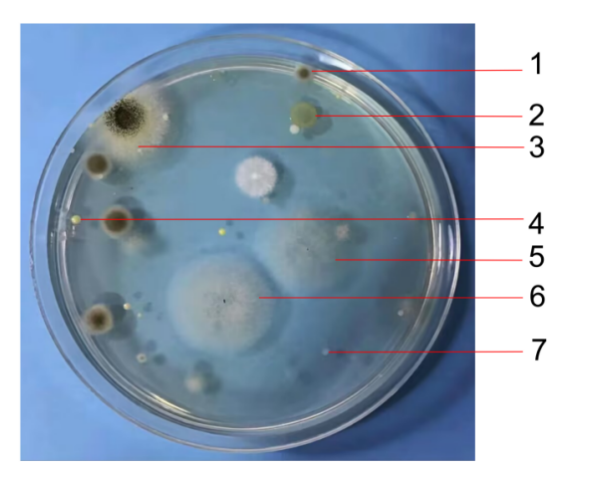
4B984
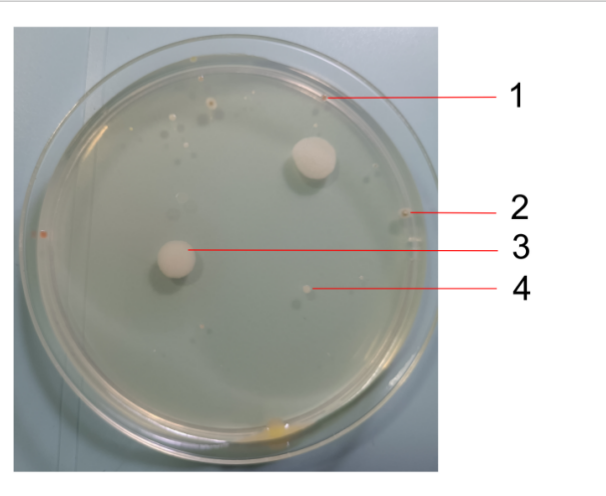
396FB

不同环境下空气微生物的差异性
不同环境下空气微生物的差异性
高一杰 高二(9)班
指导老师:张莹 小组成员:蒋卓臻、吕自平
1提出问题
空气微生物与人体健康密切相关,病原微生物易诱发呼吸道疾病甚至增加癌症风险。日常活动的家庭客厅、厕所、小区花坛、社区多功能活动室四类场所,人流量、通风条件、污染源差异显著,这些场所的空气微生物在数量、种类上是否存在明显差异?耐药菌的分布有何特点?哪些环境因素会影响空气微生物的分布?本探究围绕上述问题展开,为日常环境消杀和空气质量改善提供科学依据。
2学科原理
1.1空气微生物以气溶胶形式存在,可通过自然沉降法收集,在营养琼脂培养基中培养后形成可见菌落,依据菌落形态区分细菌、真菌。
1.2奥梅梁斯基公式为空气微生物浓度计算的核心公式,通过平板菌落数、平板面积、暴露时间等参数,可换算出单位体积空气中的微生物数量。
1.3利用青霉素的抗菌特性,搭配两性霉素B制作筛选平板,能检测出空气中对青霉素不敏感的耐药菌,原理为耐药菌可在含抗生素的培养基上正常生长繁殖。
1.4微生物的基因交换机制:人员密集区域的细菌可通过质粒、性菌毛交换基因,易产生耐药性菌株,导致耐药菌占比升高。
3探究过程
3.1监测对象:选取家庭客厅、厕所、小区花坛、社区多功能活动室四类场所。
3.2实验材料:配制牛肉膏蛋白胨固体培养基,高压蒸汽灭菌;20mg/L 青霉素与两性霉素 B 混合液用于耐药菌筛选。
3.3采样方法:按对角线 / 梅花式布点,采样高度1.2米(与人体呼吸高度一致),远离门窗、空调等通风处,关闭门窗后采用自然沉降法,将培养基平板暴露5分钟后密封培养。
3.4培养与观察:37℃温箱培养72小时,观察菌落形态、大小、颜色并分类计数;利用抗生素筛选平板培养样品,检测耐药菌数量。
3.5评价标准:参照中国科学院生态中心大气微生物评价标准,判定各场所空气质量等级。
4数据处理
依据奥梅梁斯基公式计算空气微生物浓度(cfu/m³),统计各场所菌落数量及占比:厕所细菌59个、真菌4个,总浓度9907.99,轻度污染;活动室细菌18个、真菌15个,总浓度5189.93,轻度污染;家庭客厅总浓度3931.74、小区花坛3744.48,均为较清洁。耐药菌占比中,厕所32.2%、活动室27.8%、小区花坛仅9.5%,活动室和厕所耐药菌占比约为野外的2.5倍。真菌占比则活动室最高(83.3%),厕所最低(6.8%)。
5结论
5.1四类场所空气微生物均以细菌为主、真菌次之,菌落形态随环境不同呈现明显差异,厕所菌落种类最多,小区花坛最少。
5.2空气微生物污染程度:厕所>活动室>家庭客厅>小区花坛,人流量大、通风差、存在污染源的场所,微生物浓度显著偏高。
5.3耐药菌主要分布在人员密集场所,厕所和活动室耐药菌占比远高于户外,推测与细菌基因交换频率相关。
5.4污染源会影响微生物种类占比,厕所因粪便污染源,细菌含量远超真菌;紫外线较强时,真菌占比会有所上升。
6创新建议
6.1场所消杀:厕所、社区活动室作为重点污染区域,增加消杀频次,采用含氯消毒剂定期喷洒;同时多开窗通风,每日进行桌面、地面消毒,降低微生物浓度。
6.2耐药菌防控:社区活动室、家庭等人员密集场所,减少抗生素的不合理使用,避免环境中耐药菌进一步滋生。
6.3环境优化:家庭客厅、社区多功能活动室可摆放绿萝、吊兰等绿植,吸附空气中的微生物气溶胶;小区增加绿化面积,利用绿植改善周边空气质量。
6.4监测优化:采用沉降法与空气采样仪结合的方式,弥补自然沉降法对小粒径微生物采样的不足,提高监测数据的准确性。
附录1:支撑材料
一、数据记录表
检测场所 |
厕所 |
社区活动室 |
家庭客厅 |
小区花坛 |
细菌数(个) |
59 |
18 |
18 |
21 |
真菌数(个) |
4 |
15 |
7 |
3 |
总菌落数(个) |
64 |
33 |
25 |
24 |
表1 各场所空气微生物菌落数量统计(单位:个)
表
表2 各场所空气中微生物含量(单位:cfu/m3)
检测场所 |
厕所 |
社区活动室 |
家庭客厅 |
小区花坛 |
空气微生物浓度 |
9907.99 |
5189.93 |
3931.74 |
3744.48 |
空气质量 |
轻度污染 |
轻度污染 |
较清洁 |
较清洁 |
图
二、实验照片
1.家庭客厅空气微生物菌落形态实拍图(标注 5 类菌落类型及关键特征)
图1 家庭客厅
菌落类型1:真菌;大小:最大菌种直径可达 7mm。特征:颜色最外圈为不透明的白色,向内 2mm 后变为墨绿色,菌落整体呈圆形,边缘较为完整,个别菌落由于发育情况不同,有的边缘出现毛状,菌落整体呈凸透镜状隆起。
菌落类型2:细菌;大小:最大直径可达 4mm。特征:颜色为较为鲜艳的红色,整体近似呈圆形,边缘较为完整,表面具有较强的反光,整体来讲呈凸透镜状的隆起。酶触实验阳性。
菌落类型3:细菌菌落。大小:最大直径约为 5mm,菌落外表面的最边缘为较深的白色,内部为较浅的白色。菌落整体呈现不规则形,边缘较为光滑,表面极其粗糙,推测该菌可以产生孢子或芽孢。
菌落类型4:真菌;大小:直径最大可为 4mm。
特征:颜色最外圈为几乎透明,向内 1mm 后变为不透明的白色。菌落整体呈较为完整的圆形,边缘呈毛状,整体呈脊凸状突起。
菌落类型5:细菌;大小:最大菌落直径约为3mm。
特征:颜色为白色,菌落整体呈圆形,边缘光滑。菌落具有较强的反光,隆起不明显,呈凸透镜状隆起。
2.厕所空气微生物菌落形态实拍图(标注 7 类菌落类型及关键特征)
图2 厕所菌落
菌落类型1:细菌菌落;大小:最大菌落直径为3mm。特征:菌落整体呈圆形,外边缘较为完整,极其光滑,但凸起不明显。颜色白色,发育较好的菌落中间会偏黄。酶触实验阳性。
菌落类型2:真菌菌落。大小:最大个体直径为8mm。特征:菌落整体呈规则的圆形,边缘随个体差异不同,个体生长情况不同,可为较为完整的圆形至丝状的一个过渡。外圈约 1mm 处为不透明的白色,向内部渐变为墨绿色。
菌落类型3:褪色为真菌。大小:菌落直径不规则,个体长,而直径约为 6mm。特征:菌落边缘呈波状,菌落边缘约 0.5mm 处为无色,在菌落中间形成黄色网状结构,并且略微隆起。
菌落类型4:真菌。大小:直径为 30mm,生长极其迅速,在半天时间内向外扩张 4mm。特征:呈较为规整的圆形,边缘呈毛状,菌落整体呈枕状突起,菌丝极其蓬松,可以用接种针轻易挑出菌落,整体呈白色。
菌落类型5:大小:最大直径为 3mm。特征:菌落颜色为较深的黄色,菌落整体呈较为规则、完整的圆形,边缘呈啮蚀状。菌落表面极不光滑,反射率较低,并且可见大量颗粒,推测为芽孢。酶触实验阳性。
菌落类型6:菌落细菌。大小:最大个体直径约为 3mm。特征:表面周围 1mm 处为透明的白色,中间偏红菌落整体呈较均匀圆形,边缘完整。菌落凸起不明显,呈凸透镜状突起。酶触实验阳性。
菌落类型7:细菌;大小:最大直径 3mm。特征:整体为圆形,边缘光滑完整,菌落为凸透镜状突起,外表较光滑有较为强烈的反光。酶触实验阳性。
3.社区活动室空气微生物菌落形态实拍图(标注 7 类菌落类型及关键特征)
图3 社区活动室菌落
菌落类型1:大小:直径最大为 7mm。特征:外圈约 1mm 处为白色,内圈为墨绿色。菌落整体呈凸透镜状隆起。 值得注意的是,该菌落表面并未出现如灰色虚线边框菌落中的粒状孢子囊,而是呈现丝状的孢子囊。
菌落类型2:大小:菌落直 径 6mm , 菌 落 外 圈 1mm。特征:为较深的黄色,内圈为较浅的黄色。菌落整体未有明显凸起,表面有较多纹理,推测形成芽孢。菌落表面较粗糙,不光滑,没有明显的反光现象。
菌落类型3:大小:菌落半径约为 12mm,具体直径由于生在培养基边缘无法测得其真实直径。特征:菌落外沿呈白色,在向内约 6mm处转为墨绿色。菌落外表面可看见大量的灰绿色颗粒,推测为孢子。
菌落类型4:细菌。大小:最大直径为 3mm 。特征:菌落整体呈圆形,边缘完整,表面较为光滑,具有较为明显的反光,拥有枕状突起,数量 8 个。细菌颜色明黄色。
菌落类型5:真菌。大小:最大直径约为8mm。特征:菌落外观整体呈圆形,但边缘为毛状。菌落微微隆起,呈凸透镜状分布。值得注意的是,由黄色虚线边框标记的菌落与红色虚线边框标记的菌落,较大的不同之处就在于其隆起的厚度不同。
菌落类型6:真菌菌落。大小:最大菌落直径可达 22mm。特征:菌落外缘呈较为规则的圆形,但边缘为毛状。菌落总体而言几乎不隆起。颜色为白色。
菌落类型7:大小:最大为 3mm。特征:为白色,中心偏黄。菌落整体呈圆形,边缘完整,具有较强的反光,隆起不明显,呈凸透镜状隆起。数量 9 个。
4.小区花坛空气微生物菌落形态实拍图(标注 4 类菌落类型及关键特征)
图4 小区花坛
菌落类型1:细菌;大小:最大直径可达 4mm。特征:菌落边缘透明,向内变为红色,菌落呈圆形,边缘完整,成枕状突起,上表面光滑。酶触实验阳性。
菌落类型2:真菌;大小:最大直径可达 6mm。特征:菌落边缘成白色,最内成墨绿色,菌落成圆形,边缘较为完整,菌落成脐突状突起。
菌落类型3:细菌;大小:最大直径可达 12mm。特征:菌落整体为不透明的白色,近似为圆形,边缘完整,菌落成凸透镜状隆起 ,上表面较为粗糙。酶触实验阳性。
菌落类型4:细菌;大小:最大直径为 5mm。特征:菌落成不透明的白色,为圆形,边缘完整,菌落成凸透镜状隆起,表面较为光滑,有反光。酶触实验阳性。
三、示意图
1. 空气微生物采样及培养流程示意图
培养基制备→高温灭菌→现场采样(平板暴露 5min)→密封培养(37℃/72h)→菌落观察→计数统计→耐药菌筛选,标注各步骤核心操作要求。
2. 各场所空气微生物类型占比示意图
以柱形图形式分别展示厕所、活动室、客厅、小区花坛的细菌、真菌占比,直观呈现各类微生物分布差异。

四、计算过程
1.核心公式(奥梅梁斯基公式)
根据奥梅梁斯基公式计算空气细菌总数。奥梅梁斯基建议,面积为 100cm2的平板培养基,暴露于空气中5min,于 37℃恒温箱培养 24h 后所生长的菌落数相当于 10L 空气中的细菌数:
空气中细菌数(cfu/m3)=1000×[(100/A)×(5/t)×(1/10)]×N=50000N/(A×T)
式中:A:平板面积(cm2),T:平板暴露时间(min),N:平均菌落数(cfu/平米)。
示例计算(以厕所为例):
已知:厕所平均菌落数 N=64 个,平板面积 A=90cm²(常规培养皿),暴露时间 T=5min
代入公式:50000×64÷(90×5)=3200000÷450≈9907.99(cfu/m³)
其他场所计算逻辑
社区活动室活动室:50000×33÷(90×5)=1650000÷450≈5189.93(cfu/m³)
家庭客厅:50000×25÷(90×5)=1250000÷450≈3931.74(cfu/m³)
小区花坛:50000×24÷(90×5)=1200000÷450≈3744.48(cfu/m³)
2.耐药菌占比计算
耐药菌占细菌比例 =(耐药菌数 ÷ 细菌数)×100%
例:厕所耐药菌占比 = 19÷59×100%≈32.20%
五、简易模型草图
空气微生物传播及耐药性产生简易模型
1.微生物气溶胶传播路径:
污染源(如厕所粪便、人体飞沫)→空气→沉降至物体表面/被人体吸入
2. 细菌耐药性产生示意图:人员密集环境中,不同细菌通过质粒 / 性菌毛进行基因交换,基因交换→耐药菌株产生→耐药菌扩散”
附录2:学科融合清单
数学(数据统计、浓度计算、比例分析、图表绘制)
生物学(微生物培养、菌落形态识别、细菌耐药性、微生物基因交换、气溶胶传播)
化学(培养基成分配置、高温灭菌原理、消毒剂作用机制、抗生素筛选原理)
物理学(空气动力学、微生物气溶胶沉降原理、气流对采样的影响)
环境科学(空气质量评价、环境污染物分布、场所消杀与环境治理)
